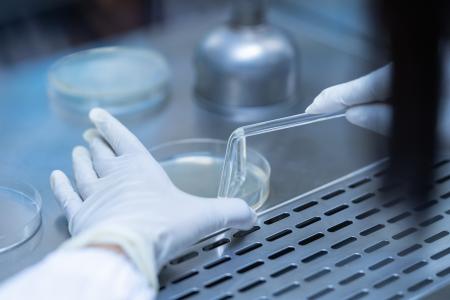
Modifier le système immunitaire du corps grâce à une greffe, pour traiter définitivement un diabète de type 1  (Visuel Adobe Stock 279923619)

DIABÈTE de TYPE 1 : Une greffe d’îlots sans immunosuppresseurs à vie
Modifier le système métabolique par une greffe, pour traiter définitivement un diabète de type 1 -une maladie auto-immune- c’est la stratégie proposée par une équipe d’endocrinologues de l'Université du Missouri (MU) – Columbia, de Harvard et de la Georgia Tech : il s’agit précisément -et à nouveau – de la greffe de cellules pancréatiques qui produisent de l'insuline mais sans besoin d’un recours aux immunosuppresseurs à vie. La procédure permet même d'entraîner le système immunitaire à accepter les cellules transplantées.
Chez les personnes diabétiques de type 1, le système immunitaire fonctionne de manière anormale et s’attaque lui-même (maladie auto-immune) rappelle l’un des auteurs principaux, le Dr Haval Shirwan, professeur de pédiatrie et de microbiologie moléculaire et d'immunologie à la MU. Alors que les injections quotidiennes d'insuline sont aujourd’hui le quotidien des millions de personnes qui souffrent de diabète de type 1, la greffe pourrait permettre de rétablir la production endogène d’insuline.
Cibler l’apoptose pour détruire les cellules immunitaires « voyous »
Diabète de type 1 et système immunitaire : le système immunitaire est un mécanisme de défense étroitement contrôlé qui assure le bien-être des individus dans un environnement truffé d'infections. Le diabète de type 1 se développe lorsque le système immunitaire identifie à tort les cellules productrices d'insuline dans le pancréas comme des infections et les détruit. Le diabète affecte ainsi la capacité du corps à produire ou à utiliser l'insuline, une hormone qui aide à réguler la façon dont la glycémie est utilisée dans le corps. La perte de contrôle de la glycémie entraîne des complications mortelles telles que des maladies cardiaques, des lésions rénales et des lésions oculaires.
- L’équipe démontre ici chez un grand modèle animal, l’efficacité de son approche de greffe d’îlots pancréatiques et sans avoir recours, à long terme, aux immunosuppresseurs.
Cibler un type d'apoptose : ce type d'apoptose se produit lorsqu'une molécule, appelée FasL, interagit avec une autre molécule appelée Fas sur des cellules immunitaires voyous, ce qui entraîne la mort des cellules immunitaires. L’équipe a donc développé une nouvelle forme de FasL et de telle manière que la molécule ne soit pas rejetée par des cellules voyous. Après la transplantation de cellules d'îlots pancréatiques producteurs d'insuline, les cellules voyous se mobilisent vers la greffe pour être détruites, mais sont éliminées par FasL engageant Fas à leur surface. La méthode permet de ne pas avoir recours, à vie, à la prise de médicaments immunosuppresseurs, qui neutralisent la capacité du système immunitaire à rechercher et à détruire un envahisseur, et dans ce cas les cellules pancréatiques greffées.
Sans les effets indésirables des immunosuppresseurs : ces médicaments, immunosuppresseurs, peuvent entraîner de nombreux effets indésirables, tels qu’une augmentation du risque de cancer. La nouvelle technologie permet de moduler ou d'entraîner le système immunitaire à accepter, et non à rejeter, les cellules transplantées.
Autres actualités sur le même thème
DÉMENCE : Le diabète, un facteur de risque majeur ?
Actualité publiée il y a 3 années 5 moisCRANBERRIES : Efficaces en 4 jours contre les maladies cardiométaboliques ?
Actualité publiée il y a 1 année 10 moisDIABÈTE : La testostérone pour réduire ses symptômes chez les hommes
Actualité publiée il y a 3 années 10 moisALCOOL et DIABÈTE : Une association entre consommation modérée et risque réduit ?
Actualité publiée il y a 8 années 8 mois
ABONNEMENT PREMIUM
Accédez sans limite à plus de 15 000 actualités




